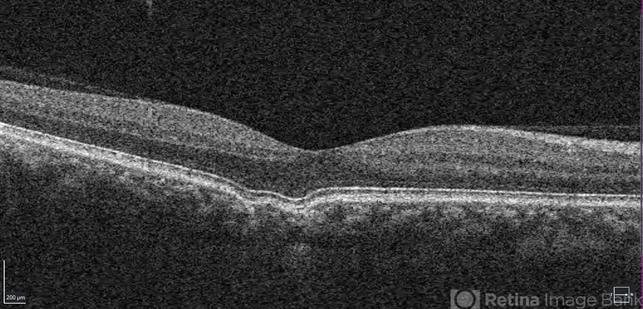
file

-
By Theodore Leng, MD, MS, FASRS
Byers Eye Institute at Stanford University School of Medicine - Uploaded on Sep 14, 2017.
- Last modified by Caroline Bozell on Sep 15, 2017.
- Rating
- Appears in
- Miscellaneous
- Condition/keywords
- excavation
- Description
- Focal choroidal excavation.

Initializing download.
Initializing download.


